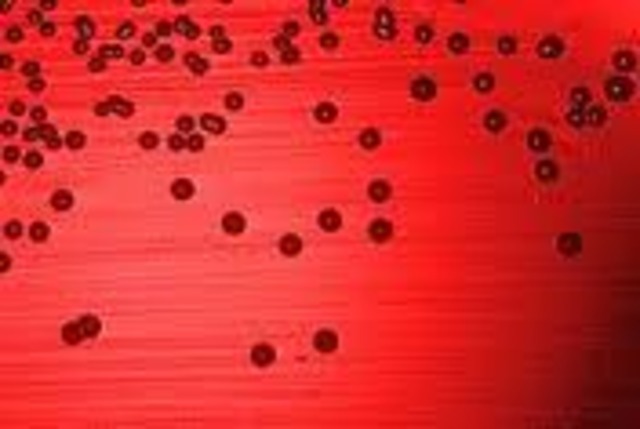
First Patent On A Living Organism

-
- Johannes Gutenberg was the inventor of this revolutionary machine.
- A device to evenly print ink onto a paper or cloth.
-
- An act of Parliament of Great Britain.
- First statute to provide for copyright regulated by the Gov and courts, instead of private parties.
-
- An English court decision that held there is a perpetual common law copyright and that no works ever enter the public domain.
- A major victory for the bookseller monopolies.
-
- The record Player or Phonograph was invented by Thomas Edison.
- It was one of the dominant audio recording formats throughout most of the 20th century.
-
- The earliest films were simply one static shot that showed an event or action with no editing or other cinematic techniques.
- The scenes were later broken up into multiple shots photographed from different distances and angles.
-
- History of technology that produced radio instruments that use radio waves.
- Many people contributed with different theories and inventions in what later became radio.
-
- A company held the copyright in a drawing of a hand, holding a pencil, and drawing a check-mark into a box. -The drawing was used on voter cards to help the illiterate in voting. A rival company produced a card with a similar but not identical drawing of a hand drawing a check-mark in a box. They were sued for copyright infringement.
-
The first patent for a human product was granted on March 20, 1906, for a purified form of adrenaline. It was challenged and uphealf in Parke-Davis v. Mulford Judge Hand argued that natural substances when they are purified are more useful than the original natural substances.
-
Emiliano Zapata Salazar was a leading figure in the Mexican Revolution. He was also directed towards Porfirio Diaz.
-
- Used for transmitting and receiving moving images that can be colored, with or without accompanying sound.
- The first images transmitted electrically were sent by early mechanical fax machines, developed in the 19th century.
-
- A video camera is a category of movie camera that captures images electronically.
- The lens of a camera captures the light from the subject and brings it to a focus on the film or detector.
-
- Is an American trade association that represents the six big Hollywood studios.
- The group adopted the Motion Picture Production Code, popularly known as the "Hays Code" in 1930.
-
- It wasn't protected until they become international agreements.
- It's "frozen" and will remain like that until 2018.
-
The General Agreement on Tariffs and Trade (GATT) Tuna-Dolphin I and Tuna-Dolphin II disputes, were two cases involving United States embargoes on yellowfin tuna and yellowfin tuna products imported from Mexico and other countries, that use purse seine fishing methods which have resulted in a high number of dolphin kills. It has been the preferred fishing technology of choice for many parts of the world over the last three decades.
-
- The public was first introduced to the concepts that would lead to the Internet when a message was sent over from UCLA to SRI.
- The Internet has had a revolutionary impact on culture and commerce, including the rise of near-instant communication by electronic mail and instant messaging.
-
- Also known as the Recording Industry Association of America.
- The RIAA is a trade organization that represents recording industry distributors in the U.S.
-
- The Philips Company of the Netherlands invented and released the first compact audio-cassette.
- They used high-quality polyester 1/8-inch tape produced by BASF. Recording and playback was at a speed of 1.7/8 inches per second.
-
- Remains the primary basis of copyright law in the U.S.
- Introduced in 1976,it spells out basic rights of copyright holders.
-
- Sony prevalailed in making the first CD that has ever existed.
- The readable surface of a Compact disc includes a spiral track wound tightly enough to cause light to diffract into a full visible spectrum.
-
The North American Free Trade Agreement (NAFTA) is an agreement signed by Canada, Mexico, and the United States, creating a trilateral trade bloc in North America. It also superseded the Canada-United States Free Trade Agreement between the US and Canada.
-
Although Brazil's aggressive efforts to provide AIDS drugs to those in need did not immediately raise eyebrows internationally, they would eventually land the country in an international patent dispute. Brazil's pioneering efforts helped spark a debate over how drug companies could be given incentives to innovate, while allowing poor countries access to desperately needed drugs.
-
- When first invented in 1995, DVD was an initialism for the unofficial term digital videodisk.
- DVDs offer higher storage capacity than Compact Discs while having the same dimensions.
-
- Founded as a pioneering peer-to-peer file sharing Internet service.
- Napster made it relatively easy for music enthusiasts to download copies of songs that were otherwise difficult to obtain, like older songs, unreleased recordings, and songs from concerts.
-
- My family immigrated from Mexico to the U.S. 12 years ago.
- My parents had to spend over $30,000 just to come here and someday I hope to repay them.
-
A federal judge in San Francisco shut down this popular music swapping website because he confessed it encouraged "whole sale infringement" against music industry copyrights. Then, Napster argued that personal copying of music is protected by federal law.
-
The iPod is a line of portable media players designed and marketed by Apple Inc. They basically serve as external data storage devices.
-
Dotcom founded the file-sharing site Megaupload that the U.S. shuttered last year after accusing him of facilitating copyright fraud on a massive scale. Dotcom says he's innocent and can't be held responsible for those who chose to use the site to illegally download songs or movies.
-
Megaupload Limited is an online Hong-Kong- based company established in 2005 that ran a number online services related to file storage and viewing. The creator is Kim Dotcom.
-
The recording industry's latest assault on file sharing has netted an unusual suspect: a deceased great-grandmother from West Virginia. In a lawsuit filed in January, the RIAA accused 83-year old Gertrude Walton of sharing over 700 pop, rock and rap songs under the alias "smittenedkitten.
-
This bill was passed by the United States House of Representatives but not by Senate. The bill was the catalyst for the 2006 U.S. immigration reform protests and was the first piece of legislation passed by a house of Congress in the United States illegal immigration debate.
-
While many events led up to the invention of the iPhone, the date that the original iPhone was released was June 29, 2007. That's when the iPhone made its debut to the public and became available for consumer purchase. However, the iPhone was the latest step in a long series of research projects begun by Steve Jobs and Apple long before this date.
-
In 2009, the website’s founders were put on trial in Sweden, charged with facilitating illegal downloading of copyrighted material. They were found guilty and sentenced to a year in prison with a fine of 30 million SEK.
-
The Foxconn suicides was when eighteen Foxconn employees attempted suicide with fourteen deaths. The suicides drew media attention, and employment practices at Foxconn, a large contract manufacturer, were investigated by several of its customers including Apple and HP.
-
The iPad is a line of tablet computers designed and marketed by Apple Inc., which runs Apple's iOS operating system. The iPad has built-in Wi-Fi, and, on some models, cellular activities, and a camera.
-
The Arizona SB 1070 is a legislative Act in the US state that at the time of passage was the broadest and strictest anti-illegal immigration measure in recent U.S. history. It has received international and national attention.
-
Limewire was one of the world's most popular peer-to-peer filesharing websites, but it was shut down after a four-year legal battle with the US music industry. It is restricted from allowing the searching and sharing of copyrighted material.
-
- The Federal Court of Appeal dismissed the appeal.
- The trial judge found that the software burned into Apple's ROMs were both a translation and reproduction of the assembly language source code, thus were protected by s. 3(1) of the Copyright Act.
Want to make a timeline like this?
Use Timetoast to turn dates, events, milestones, and phases into a clear visual timeline you can build and share. Timetoast is a timeline maker for work, school, research, and stories.